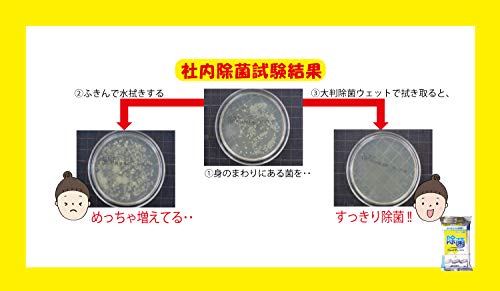
服部製紙 アルコール 除菌 ウェットティッシュ 大判シート 天然成分配合 シートサイズ約20×30cm やわらかウェットティッシュ NPF-9 20枚入 6枚目

かぶせ釣りとは、広島のカキを砕いてエサにする釣り方。クロダイ、アイナメなど、比較的大き目の美味しい魚を狙えるのが嬉しいですね。今回、釣りラボでは、かぶせ釣りのコツ、必要なタックルやおすすめの商品を紹介していきます。
かぶせ釣りの特徴

皆さんはかぶせ釣りという釣り方を聞いたことがあるでしょうか。
かぶせ釣りとは広島発祥の釣りで、昔からある釣り方です。
かぶせ釣りのやり方はまず牡蠣の殻を割って中の身に針を掛けたら殻付きのままエサにして足元に落とします。
仕掛けを落としたら砕いた牡蠣の殻を仕掛けの上に「かぶせる」ように撒きます。
狙う魚はチヌやコブダイといった大型の魚になるので、力強いファイトを楽しむことができます。
また、エサとなる牡蠣は現地調達することができるので餌代がかからないお財布にも優しい釣りです。
今回はそんなかぶせ釣りについて紹介していきたいと思います。
かぶせ釣りに使用する餌(エサ)
かぶせ釣りは元々は牡蠣を使用する釣りではありましたが、かぶせ釣りが広がると共に餌の種類も増えてくるようになりました。
基本的には現地調達ができる貝類になります。
かぶせ釣りに使用する餌について、種類と付け方を紹介します。
主に使用する餌
かぶせ釣りの主に使用する餌は、牡蠣になります。
他にアサリやイガイ、アケミ貝といった貝類も使われています。
餌の付け方
餌の付け方は、殻を割って中の身に針をチョン掛けします。
この時に掛けるのは貝の「ワタ」の部分にチョン掛けするのがポイントです。
魚はこの部分から食いつくことが多いので釣果に繋がるようです。
かぶせ釣りのターゲット
かぶせ釣りは多くの魚種を狙える釣りとしても知られています。
良く釣れる魚としてはチヌ(黒鯛)、石鯛、アイナメ、コブダイ、カワハギ、グレ(メジナ)、ベラが挙がります。
他に稀に釣れる魚としてはカレイやシロギス、メバル、スズキなどが釣れることもあります。
かぶせ釣りがおすすめの場所
かぶせ釣りは様々な場所で楽しむことができる釣りです。
牡蠣筏がメジャーなスポットですが、護岸や波止からも楽しむことができます。
かぶせ釣りができるかどうかのポイントは足元の水深が深い場所で、牡蠣が多く付着しているというところがポイントです。
また、底にゴロタといった隠れ場があると最高のポイントとなります。
かぶせ釣りがおすすめの地域
かぶせ釣りがおすすめの地域を紹介します。
一番のおすすめは何と言っても広島です。
かぶせ釣り発祥ということもありますし、餌となる牡蠣も手に入りやすいのでおすすめです。
中でも広島の呉は多くの実績もある地域です。
また、最近は九州や関東、静岡といった地域でもかぶせ釣りを楽しむ方が増えてきているのでおすすめです。
かぶせ釣りにおすすめの時期
かぶせ釣りは餌に牡蠣を使うことから、牡蠣の身が大きくなる冬場がおすすめの時期になります。
冬場を中心におおよそ10月~6月の秋から春まで長く楽しむことができます。
また、餌を牡蠣からイガイなどに変更すると夏場でもかぶせ釣りを楽しむことができます。
コブダイなどは年中釣れるので、夏でも楽しむことはできます。
かぶせ釣りにおすすめの時間帯
かぶせ釣りをするのにおすすめの時間帯は朝~昼の明るい時間帯です。
釣果もそうですが、何より水深のある場所で行う釣りなので安全面では明るい時間帯の方が絶対に良いです。
但し、足場が良い場所であれば夜も楽しめる釣りです。
チヌを狙うのであれば秋口の夜はおすすめの時間帯と言えるでしょう。
かぶせ釣りのおすすめのタックル

波止や護岸でかぶせ釣りを楽しむためのタックルを紹介していきます。
基本的には特別なタックル選びではないですが、かぶせ釣りがしやすい筏竿などを紹介しますので参考にしてみてください。
おすすめのロッド
まずはおすすめのロッドからです。
かぶせ釣りのロッドは一般的には2m前後の長さのチヌ用の筏竿を使用していきます。
【ダイワ】飛竜イカダ180
ダイワのコストパフォーマンスに優れる筏竿です。
板シートタイプとパイプシートタイプのラインナップで調子異なる2種類から選ぶことができます。
おすすめのリール
かぶせ釣りのリールは両軸リールが一般的です。
落とし込み用の片軸リールでも使用することができます。
【シマノ】セイハコウSP RC83
シマノのセイハコウSPRC83は65㎜の大口径スプールを装備した落とし込み用リールです。
クラッチ操作で宙切りや横へ流すことができるリールです。
おすすめのライン
かぶせ釣りで使うラインは道糸に2~4号のPEラインやフロロカーボンを使うと良いでしょう。
【東レ】フロロカーボンライン トヨフロン チヌ筏かかり
東レのフロロカーボンラインは耐摩耗性に優れているとの評判が高いラインです。
滑り性能も高いので、スムーズに使用することができます。
【バリバス】フロロカーボンライン 黒鯛スペシャル チヌ筏 かかり・かせ
バリバスのラインは号数以上に耐久力が高く感じるラインです。
かぶせ釣りでは大物がかかることが多いので、ラインの耐久性が高いものを選ぶようにしましょう。
かぶせ釣りにあると便利な道具

かぶせ釣りは牡蠣の殻を割ったりと、他の釣りとは少し違う釣りになります。
ここではかぶせ釣りを行うのに、あると便利な道具を紹介したいと思います。
ハンマー
牡蠣の殻を割るためのハンマーは必需品です。
小型のもので良いので用意するようにしましょう。
【高儀】ポケットハンマー ネイル
使いやすいサイズのポケットハンマーです。
釘抜があることで牡蠣を取る際にも活躍してくれますし、落下防止のコード取付穴があるのもポイントが高いです。
バケツ
かぶせ釣りでは餌の牡蠣を入れておくバケツやバッカンも必要になります。
尖った殻で傷が付くこともありますので、安価なもので良いでしょう。
【シマノ】バッカンEV BK-016Q
ガチットハンドルという機能が付いているバッカンで、ハンドルは持ち運びでも保管時にも使いやすいハンドルです。
価格もリーズナブルなのでかぶせ釣りにはぴったりです。
ランディングネット
かぶせ釣りは水面と高低差があることがほとんどです。
釣った魚を引き上げるためのランディングネットは必需品となるでしょう。
【サンライク】玉網 折り畳み式ランディングネット
肩掛けベルト付きで携行性に優れたランディングネットです。
タモ網も折りたたむことができるので簡単に持ち運ぶことができます。
拭き取るもの
細かいところですが、ウェットティッシュなどの汚れをふき取るものも合ったほうが良いでしょう。
牡蠣を触った手で触れると異臭がするようになってしまいます。
【服部製紙】除菌ウェットティッシュ 大判サイズ
20cm×30cmという大判サイズのウエットティッシュです。
大判サイズなのでアウトドアでの使用にはぴったりです。
かぶせ釣りのまとめ

いかがでしたでしょうか?
今回、釣りラボでは、「広島発祥!かぶせ釣りの方法や特徴とは?餌の付け方や仕掛けについても紹介!」というテーマに沿って、
といったことをご紹介してきました。
他にも、釣りラボでは、釣りに関連する様々な記事をご紹介しています。
もし、釣りに関してまだ知りたいことがあれば、サイト内検索をご利用いただくか、ぜひ関連する他の記事をご覧ください。
最後まで読んでいただき、誠にありがとうございました。
この記事を読んだ人はこんな記事も読んでいます